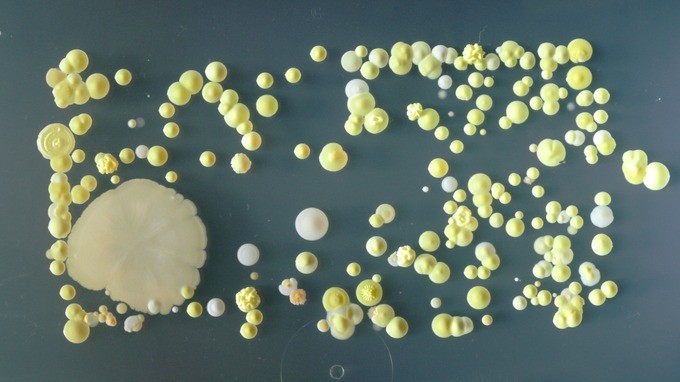

Будущие пресловутые британские ученые — студенты Университета Суррея, поставили занятный эксперимент.

Они поместили свои мобильные телефоны в благоприятную среду для развития бактерий и через три дня сняли пробы.

Выяснилось, что каждый день у нас в руках размножаются миллионы всяческих гадостных микроорганизмов, которые могут стать причиной стафилококка, пищевого отравления, импетиго и сепсиса.



|